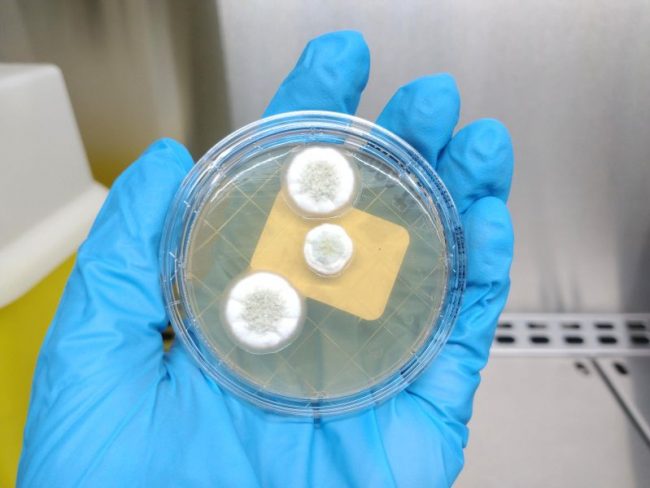
1700213125364

Análisis microbiológicos de superficies
Los análisis microbiológicos de superficies para detectar hongos son fundamentales para garantizar la seguridad en diversos entornos, ya sea para proteger la salud humana y animal, como para garantizar la calidad de productos. En la industria alimentaria, la contaminación por hongos puede afectar la calidad y seguridad de los productos. Los hongos pueden producir toxinas que, cuando están presentes en alimentos,…